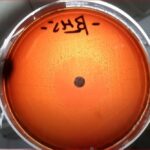
Neomycin Blood Agar: Introduction, Principle, Composition, Preparation, Procedure, Colony Morphology, Uses and Keynotes
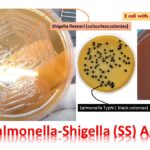
SS Agar: Introduction, Composition, Principle, Procedure, Results- Interpretation, Uses,Limitations, and Keynotes

Tag: composition
Dubos Oleic Agar: Introduction, Principle, Composition, Preparation, Procedure, Colony Morphology, Uses and Keynotes
 Introduction of Dubos Oleic Agar Dubos Oleic Agar is commonly...
Introduction of Dubos Oleic Agar Dubos Oleic Agar is commonly...
Neomycin Blood Agar: Introduction, Principle, Composition, Preparation, Procedure, Colony Morphology, Uses and Keynotes
Introduction of Neomycin Blood Agar Neomycin Blood Agar is a...
Introduction of Neomycin Blood Agar Neomycin Blood Agar is a...
SS Agar: Introduction, Composition, Principle, Procedure, Results- Interpretation, Uses,Limitations, and Keynotes
Introduction of SS Agar SS Agar is the short form...
Introduction of SS Agar SS Agar is the short form...
